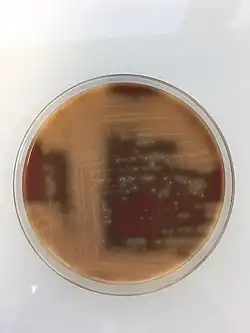

Streptococcus pneumoniae
| Domaine | Bacteria |
|---|---|
| Phylum | Bacillota |
| Classe | Bacilli |
| Ordre | Lactobacillales |
| Famille | Streptococcaceae |
| Genre | Streptococcus |
Streptococcus pneumoniae (le pneumocoque) est une espèce de bactérie du genre Streptococcus. C'est un important agent pathogène chez l'humain. Il est notamment responsable de nombreuses co-infections : il a, par exemple, aggravé la mortalité lors de la pandémie de grippe espagnole[1].
Son nom initial était Diplococcus pneumonia en 1926. Il a été rebaptisé Streptococcus pneumoniae en 1974 vu sa croissance en chaînes dans les milieux liquides. À cause de son implication comme agent pathogène dans les pneumonies, il a longtemps été dénommé simplement pneumocoque.
Les infections à pneumocoque sont particulièrement dangereuses et nécessitent très souvent une hospitalisation, avec des taux de mortalité compris entre 8 % et 15 %.
Propriétés bactériologiques

Morphologie
Observé au microscope, le pneumocoque se présente sous forme de diplocoques à Gram positifs lancéolés accolés par leur côté pointu, formant un chiffre 8. Dans les produits pathologiques, les pneumocoques pathogènes sont entourés d'une capsule bien visible[2].
Culture
- Les pneumocoques sont aéro-anaérobie facultatifs, ne possèdent pas de catalase (l'absence de catalase entraîne en culture une accumulation d'eau oxygénée qui tue le germe et c'est sans doute par l'apport de catalase que l'adjonction de sang est la plus utile).
- Développement favorisé par la présence de liquides organiques (sang).
- Leurs colonies sont transparentes, en gouttelettes de rosée, lisses (S) pour les pneumocoques virulents capsulés. La perte de la capsule entraîne à la fois la perte de virulence et la modification de la colonie qui devient rugueuse (R). Les colonies sont parfois très muqueuses chez les souches fortement capsulées, de plus ou moins 1 mm, dont le centre s'affaisse après 2 à 3 jours (autolyse).
- Sur gélose au sang frais, il n'y a pas de vraie lyse des globules rouges mais éventuellement un léger verdissement autour de la colonie (hémolyse de type alpha : transformation de l'hémoglobine en biliverdine).
- Sur gélose chocolat + polyvitex, l'hydrolyse de l'hémoglobine en biliverdine se traduit par une zone d'éclaircissement jaune-verdâtre autour des colonies.
- Ils entraînent un léger trouble du bouillon de culture.
Pour les différencier des streptocoques auxquels ils sont très apparentés, on parle de Streptococcus pneumoniae dans certaines nomenclatures, on se fonde sur les caractères suivants :
- lyse rapide par la bile à 5 % (ou sels biliaires) ;
- inhibition par l'optochine (éthylhydrocupréine) dont on peut imprégner un disque de papier buvard à déposer sur la gélose ;
- pouvoir pathogène très élevé pour la souris (septicémie mortelle en 24 heures après injection intrapéritonéale de pneumocoques capsulés).
Dans l'organisme
Streptococcus pneumoniae semble pouvoir utiliser les acides du groupe de l'acide sialique comme source de carbone, ce qui expliquerait au moins en partie sa capacité à rapidement infecter les poumons ou certains d'autres organes (s'il peut y pénétrer). Le pneumocoque ne trouve pas de sucres libres dans la trachée ou le reste de l'arbre pulmonaire, mais il peut dégrader les acides sialiques pour les transformer en sucre et s'en nourrir[3].
Sécrétions et toxines
La pneumolysine est la seule exotoxine protéique décrite chez le pneumocoque mais la pathogénie de cette bactérie repose principalement sur son pouvoir invasif.
Antigènes
Antigènes somatiques
Communs aux autres streptocoques, de nature protéique et polysaccharidique « C » (au cours des états inflammatoires plus ou moins aigus et évolutifs, il apparaît dans le sérum des malades une protéine qui réagit par précipitation avec cet antigène C : il s'agit de la protéine C réactive ou CRP[réf. nécessaire].)
Antigènes capsulaires
Également polysaccharidiques, dont la diversité antigénique permet de distinguer plus de 90 types de pneumocoques[4]. 75 % des infections respiratoires sont dues au type I, II, III (le plus virulent), V et VIII.
C'est l'étude de ces antigènes capsulaires qui fut le départ de la génétique bactérienne. Griffith avait constaté en 1928 que si on injecte à une souris un pneumocoque R (non capsulé) ainsi qu'une petite quantité de pneumocoques S tués, la souris meurt et on récupère des pneumocoques S (capsulés) dans son sang. De plus, si la souche R dérive d'un pneumocoque de type I par exemple, et qu'on y ajoute du pneumocoque de type S tué de type II, les pneumocoques capsulés que l'on récupère seront du type II.
Oswald Avery, en 1943, démontra que c'est l'ADN du pneumocoque lisse tué qui induit cette « transformation ».
C'est donc bien la possession d'une capsule avec son antigène spécifique de type qui confère sa virulence au pneumocoque. Seuls les anticorps anticapsulaires confèrent une immunité valable. In vitro, les leucocytes ne phagocytent les pneumocoques encapsulés qu'en présence d'anticorps spécifiques de type capsulaire.
La détermination de type d'un pneumocoque était essentielle à l'époque où la sérothérapie constituait le seul traitement efficace à condition bien sûr d'utiliser le sérum correspondant au type en cause. La méthode la plus simple se fondait sur le phénomène de Neufeld : si l'on émulsionne un pneumocoque encapsulé (produit pathologique ou culture) dans une goutte d'antisérum, on observe un très net épaississement de la capsule si le type de celle-ci correspond au sérum employé.
La compétence chez Streptococcus pneumoniae
La compétence chez Streptococcus pneumoniae est contrôlée par la détection du quorum ou quorum sensing.
L’induction de la compétence chez S. pneumoniae est divisée en deux phases dans le temps. La phase « précoce » et la phase « tardive », régulées respectivement par ComE ~ P et ComX.
À mesure que la population de bactéries se développe, la concentration en auto-inducteurs CSP (peptide stimulant la compétence) augmente proportionnellement. Une fois le seuil de concentration critique atteint, le CSP extracellulaire se lie et active le récepteur ComD de l’histidine kinase correspondante. L'activation de ComD entraîne son auto-phosphorylation et la phosphorylation de ComE, un régulateur de réponse cytosolique.
ComE phosphorylé se lie à une séquence de promoteur conservée Ceb et active la transcription de ComX, ComAB et ComCDE, ComE. ComE est responsable de l’activation d'au moins 17 autres gènes nécessaires au développement de l'état compétent. L'activation de la transcription génique de son propre gène et du gène codant le CSP, ComC induit la surproduction du signal auto-inducteur (CSP), conduisant ainsi à une boucle de rétroaction positive permettant de synchroniser sa perception au sein de la population bactérienne et, garantissant à toutes les cellules de la population de devenir compétentes.
Les niveaux d'expression des gènes précoces induits par ComE atteignent un pic entre 7,5 et 10 min après l'induction de la CSP extracellulaire[5].
Quant à ComX, il active la RNAP (ARN polymérase) qui transcrit les gènes tardifs nécessaires à l'absorption et à l'intégration de l'ADN. Les niveaux d'expression des gènes tardifs induits par ComX atteignent un pic environ 12,5 à 15 min après l'induction de la CSP[5]. Les gènes tardifs comprennent plus de 80 gènes, dont 14 identifiés comme essentiels pour la transformation[5].
La fonction du ComAB est d'exporter et clivé ComC en un CSP actif.
Écologie, rôles pathogènes et épidémiologie
Le pneumocoque est la cause la plus commune de méningites bactériennes communautaires chez l'adulte[6],[7] et il est l'un des deux principaux agents mis en cause dans les otites.
Chez les enfants, les infections invasives à pneumocoque concernent surtout la tranche d'âge avant 2 ans et peuvent conduire à des pneumonies et des méningites. Cette dernière entraîne une mortalité dans 8 % à 15 % des cas, et des séquelles fréquentes : épilepsie, surdité, parésie. Le germe est responsable d'un peu plus de 10 % de la mortalité de l'enfant de moins de 5 ans, essentiellement dans les pays du tiers-monde, ce qui constitue un problème de santé publique majeur[8]. Chez les enfants, les maladies favorisant les infections invasives à streptococcus pneumoniae sont l'asplénie, la drépanocytose, le HIV, mais aussi les déficits immunitaires congénitaux, les cardiopathies congénitales cyanogènes, l'insuffisance cardiaque, l'insuffisance rénale et le syndrome néphrotique, les pneumopathies chroniques, le diabète, les traitements immunosuppresseur et radiothérapique, les brèches cérébroméningées. Au début du XXIe siècle, les infections à pneumocoque tuaient près de 800 000 enfants par an dans le monde[9].
Le pneumocoque est présent comme commensal des voies respiratoires chez 5 à 10 % des individus normaux, généralement en petit nombre (antagonisé par le Streptococcus viridans). Il est plus fréquent (25 à 60 %) et plus abondant chez les patients atteints de bronchite chronique sans que son rôle pathogène dans cette maladie soit nettement établi : il est généralement associé à des bacilles hémophiles.
Ces formes commensales n'ont généralement pas de capsule, contrairement aux formes virulentes qui peuvent causer notamment :
- la pneumonie franche lobaire aiguë (communautaire), surtout chez l'adulte affaibli (infection virale, lésion respiratoire par gaz toxique, atélectasie, asthme, etc.) ou alcoolique (l'alcool supprime le réflexe tussigène et déprime la phagocytose) ; la pneumonie lobaire est souvent accompagnée de bactériémie pouvant se compliquer en méningite ;
- des bronchopneumonies, (dont des exacerbations de BPCO) surtout chez l'enfant et le vieillard, souvent complications d'infections virales (grippe) ;
- des pleurésies purulentes (empyèmes) compliquant les deux maladies précédentes ;
- des sinusites, otites, conjonctivites ;
- des méningites ;
- une cellulite à pneumocoque, plus rarement, et qui peut révéler un myélome[10].
Ces diverses infections s'accompagnent de réactions fibrineuses qui entraînent des cloisonnements difficiles à traiter.
Assez fragile dans les milieux extérieurs, ce germe se transmet surtout par les particules de salive des malades et porteurs sains par contact direct ou indirect avec les sécrétions du nez ou de la gorge d’un porteur (baiser, toux, éternuements)[11].
Au point de vue épidémiologique, la fréquence des pneumonies lobaires a nettement baissé (hygiène générale, chimiothérapie); les autres localisations restent relativement fréquentes. Il faut noter une susceptibilité plus élevée des personnes à la peau noire vis-à-vis de ce germe[réf. nécessaire].
Méthodes de diagnostic
Examen microscopique
La présence de diplocoques capsulés (dans le crachat rouille de la pneumonie lobaire, le liquide cérébrospinal, dans des hémocultures, du pus de sinusite...) permet un diagnostic d'autant plus sûr et précis que les germes sont abondants et constituent l'unique flore observée.
Culture et identification

Par la sensibilité à l'optochine et aux sels biliaires
L'inoculation intrapéritonéale à la souris
Il permet l'isolement à partir d'une flore mixte.
Sérologie
La recherche d'anticorps dans le sang du malade ne présente guère d'intérêt (trop tardive) mais on peut éventuellement révéler dans le sang ou le LCR la présence de l'antigène capsulaire en employant un sérum antipneumococcique spécifique ou polyvalent (contre-immunoélectrophorèse).
Traitement
Les pneumocoques sont, jusqu'à maintenant, généralement bien sensibles à la majorité des antibiotiques, sauf aux aminoglycosides. Les pénicillines, les sulfamidés, les macrolides sont actifs sur tous les pneumocoques, quel que soit leur type. On observe une résistance relative aux tétracyclines comme pour les streptocoques.
Malheureusement, comme la plupart des germes, la résistance aux antibiotiques se diffuse progressivement et on comptait jusqu'à un quart des souches résistantes à la pénicilline aux États-Unis en 1998[12].
Prévention

Il existe plusieurs types de vaccins antipneumococciques :
- le vaccin conjugué, immunisant pour 13 sous-types (sérotypes) de pneumocoque (Prevenar 13). Aux États-Unis, l'utilisation à grande échelle de ce vaccin, chez les jeunes enfants, a entrainé une forte baisse des infections invasives à pneumocoques (sérotypes contenus dans le vaccin), chez les enfants vaccinés, et plus globalement des pneumonies nécessitant une hospitalisation[13], mais aussi, dans une moindre mesure, chez les enfants non vaccinés, dans la population générale et les plus de 50 ans. En France, la vaccination est obligatoire (depuis 2018) pour tous les nourrissons dès l'âge de deux mois. Pour les enfants de plus de deux ans, la vaccination est recommandée lorsqu'il existe une maladie favorisant les infections à pneumocoque[14] : brèches cérébroméningées, asplénie, déficit immunitaire, cardiopathies congénitales cyanogènes, pneumopathies chroniques sauf asthme et diabète. Ce vaccin n'a pratiquement pas d'efficacité sur la prévention des otites ;

- le vaccin polysaccharidique, immunisant pour 23 sous-types de pneumocoque et apparu en 1983, utilisé dans les situations à risques, en vaccination de l'adulte et de l'enfant de plus de cinq ans (voir ci-dessus) (Pneumo 23). C'est ce type de vaccin qui est recommandé par l'OMS dans les indications précisées[15]. Son efficacité réelle est toutefois, controversée[16]. Au Royaume-Uni, le , les autorités ont recommandé l'abandon du vaccin polysaccharidique en vaccination de routine pour les plus de 65 ans[17]. Elles sont revenues sur leur décision depuis, confirmant l'intérêt de ce vaccin chez les plus de 65 ans ()[18].
Notes et références
- ↑ (en) David M. Morens, Jeffery K. Taubenberger et Anthony S. Fauci, « Predominant Role of Bacterial Pneumonia as a Cause of Death in Pandemic Influenza: Implications for Pandemic Influenza Preparedness », The Journal of Infectious Diseases, vol. 198, no 7, , p. 962–970 (ISSN 0022-1899 et 1537-6613, PMID 18710327, PMCID PMC2599911, DOI 10.1086/591708, lire en ligne, consulté le )
- ↑ Celle-ci est visible car elle n'est pas colorée par les colorants classiques. Ainsi, les pneumocoques sont entourés d'un halo incolore dans les produits pathologiques
- ↑ (en) Carolyn Marion, Amanda M. Burnaugh, Shireen A. Woodiga et Samantha J. King, « Sialic Acid Transport Contributes to Pneumococcal Colonization », Infection and Immunity, vol. 79, no 3, , p. 1262–1269 (ISSN 0019-9567 et 1098-5522, PMID 21189320, PMCID PMC3067482, DOI 10.1128/IAI.00832-10, lire en ligne, consulté le )
- ↑ En 2016, au moins 92 sérotypes étaient connus
- 1 2 3 Erin Shanker et Michael J. Federle, « Quorum Sensing Regulation of Competence and Bacteriocins in Streptococcus pneumoniae and mutans », Genes, vol. 8, no 1, (ISSN 2073-4425, PMID 28067778, PMCID PMCPMC5295010, DOI 10.3390/genes8010015, lire en ligne, consulté le )
- ↑ « Méningite aiguë de l'adulte » sur http://www.vidalrecos.fr : « L'incidence des méningites bactériennes est de 2,5 cas pour 100 000 habitants en France. Trois germes sont le plus souvent en cause. Streptococcus pneumoniae (pneumocoque) est le plus fréquent (49 % des cas en 2002), avec une mortalité de 20 à 40 %. Neisseria meningitidis (méningocoque) est responsable de 33 % des cas avec une mortalité de 5 % ; Listeria monocytogenes de 4 % des cas avec une mortalité de 20 à 30 %. »
- ↑ Infections invasives à H. influenzae, L. monocytogenes, N. meningitidis, S. pneumoniae, S. agalactiae et S. pyogenes en France en 2001-2002 sur http://www.invs.sante.fr : « Chez les enfants jusqu’à l’âge de deux mois, on observe principalement des méningites à streptocoque du groupe B (82,5 %), de deux mois à deux ans des méningites à S. pneumoniae (47 %) et à N. meningitidis (48 %) ; de trois à vingt-quatre ans, N. meningitidis (75 %) est la principale cause des méningites. Après vingt-cinq ans, S. pneumoniae est le principal organisme responsable des méningites en France (de 60 % entre vingt-cinq et trente-neuf ans à 72 % après soixante quatre ans). »
- ↑ O'Brien KL, Wolfson LJ, Watt JP, Burden of disease caused by Streptococcus pneumoniae in children younger than 5 years: global estimates, Lancet, 2009;374:893-902
- ↑ Cynthia Gorney, « Vaccins encore des millions d'enfants à sauver », National Geographic, France,
- ↑ Durupt, S., Durieu, I., Nove-Josserand, R., Dumontet, C., Tognet, E., & Durand, D. V. (2000). Cellulite à pneumocoque révélant un myélome. La Revue de médecine interne, 21(5), 464-465.
- ↑ (en) « Méningite à pneumocoques », sur www.meningitis.ca (consulté le )
- ↑ (en) Whitney CG, Farley MM, Hadler J. et al. « Increasing prevalence of multidrug-resistant Streptococcus pneumoniae in the United States » N Engl J Med. 2000;343:1917-24.
- ↑ CG Grijalva, JP Nuorti, PG Arbogast, SW Martin, KM Edwards, MR Griffin, « Decline in pneumonia admissions after routine childhood immunisation with pneumococcal conjugate vaccine in the USA: a time-series analysis » Lancet 2007;369;1179-1186.
- ↑ selon l'avis du CSHPF : Conseil supérieur d'hygiène publique de France
- ↑ (en) WHO, « 23-valent pneumococcal polysaccharide vaccine: WHO position paper » Weekly epidemiological record. 2008;83:373-384.
- ↑ (en) Huss A, Scott P, Stuck AE, Trotter C, Egger M, « Efficacy of pneumococcal vaccination in adults: a meta-analysis » CMAJ. 2009;180:48-58.
- ↑ (en) « JCVI issues preliminary advice on pneumococcal polysaccharide vaccination… », sur nelm.nhs.uk via Wikiwix (consulté le ).
- ↑ http://www.dh.gov.uk/prod_consum_dh/groups/dh_digitalassets/documents/digitalasset/dh_128537.pdf
Liens externes
- (en) LPSN : Streptococcus pneumoniae (Klein 1884) Chester 1901 (Approved Lists 1980) (consulté le )
- Portail de la microbiologie
- Portail de la médecine